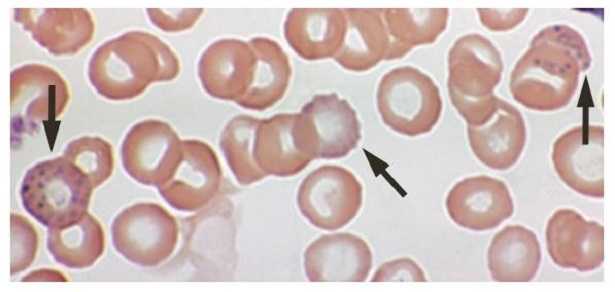
Saturnismo

Saturnismo, deriva da “Saturno”, dio romano che per i greci si chiama Crono, associato al Piombo, ed è il termine per definire l’avvelenamento da piombo. Questo metallo può creare dei gravi danni al nostro organismo se lo assimiliamo, ciò può avvenire in vari modi. Per vie cutanee, attraverso le mucose, per inalazione oppure perché lo ingeriamo e lo digeriamo. Quando le quantità che assimiliamo sono esagerate, possiamo parlare di saturnismo.
Purtroppo con il piombo è difficile non entrare mai in contatto nemmeno per sbaglio perché è piuttosto utilizzato e a volte anche per fini pratici virtuosi. E’ un metallo malleabile e pesante di colore grigio scuro, usato anche in lega con altri metalli, oltre che puro, e per la produzione di composti inorganici.
Saturnismo: sintomi
I maggiori danni creati dal piombo riguardano il sistema nervoso, con malattie al cervello e al sangue, soprattutto se le vittime sono bambini.
Il saturnismo dovuto ad una esposizione al piombo o ai suoi sali, arriva a provocare nefropatie e dolori addominali colici, sintomi che possiamo ritrovare anche in persone che bevono in quantità inopportune degli alcolici di contrabbando perché possono contenere questo metallo a a causa di una distillazione “ a base di piombo”, oppure in chi cucina con stoviglie smaltate a piombo. Le categorie più a rischio però sono i lavoratori dell’industria e dell’artigianato.

Saturnismo: rimedi
La prima cosa da fare è allontanarsi dalla fonte e allo stesso tempo provvedere alla somministrazione di un chelante del piombo. Se tra i sintomi ci sono anche le coliche, possiamo utilizzare degli spasmolitici in modo da non soffrire troppo per questi dolori, ci sono anche dei farmaci specifici che possono intervenire se il piombo ha causato disionia ed ipertensione.
Sono in corso anche degli studi per indagare le caratteristiche dell’alga spirulina. Si ipotizza che possa essere considerato un chelante del piombo e l’idea sarebbe quella di usarlo per la depurazione delle acque di scarico. Certo va verificato che questa alga non sia stata a sua volta coltivata in acque contaminate, altrimenti è ovvio e inevitabile che non avrà i benefici che ci aspettiamo.
Prima di arrivare ad intossicarsi con il piombo, in generale il nostro organismo in piccole dosi lo elimina attraverso le feci. Analizzando invece le urine si può fare una stima della dose assorbita, il piombo può però raggiungere purtroppo anche il latte materno o la placenta
Saturnismo: cause
Se ingeriamo alimenti contaminati, possiamo ammalarci di saturnismo ma anche se controlliamo con attenzione ciò che serviamo in tavola, non siamo fuori pericolo. Il nostro corpo può assimilare questo velenoso metallo anche respirandolo, come ben sa chi vive in una zona inquinata.
Il piombo penetra per vie cutanee, attraverso le mucose, come nel caso dei tanti professionisti che ci lavorano sa mattino a sera: chi si occupa di estrazione o fusione del piombo, di saldatura, di produzione o smaltimento di accumulatori, chi maneggia le vernici o gli oggetti di cristallo, chi lavora per produrre pallini da caccia o i restauratori.
Tra le categorie a rischio c’è anche chi beve distillati prodotti in modo clandestino e senza seguire le corrette procedure di distillazione e conservazione.
Se di professione facciamo tutt’altro, attenzione all’aria che respiriamo, al suolo che calpestiamo e all’acqua che beviamo. Il saturnismo non è diffusissimo perché è la fase davvero grave dell’avvelenamento da piombo, ma questo metallo è davvero molto presente nella nostra vita.

Saturnismo: bambini
I bambini sono a rischio di avvelenamento più degli adulti, già ancora prima di nascere, perché questo metallo viene veicolato anche nella placenta, e in fase di allattamento, perché può “contaminare” il latte materno. L’età pericolosa non è finita perché quando un bimbo comincia a mettere in bocca ciò che trova, è da tenere sott’occhio essendo anche più sensibile alle piccole dosi di metallo che può ingerire mordendo oggetti che ne contengono.
Quando il piombo entra a diretto contatto con la gengiva, è un problema, non immediato ma che alla lunga può causare danni seri al piccolo.
Saturnismo e anemia
L’anemia è uno dei sintomi del saturnismo, magari non il più diffuso ma nemmeno il più raro. Quando il piombo viene assorbito, si distribuisce in larga parte negli eritrociti e solo in minima parte nel plasma per poi arrivare ai tessuti molli, alle osso e a capelli e denti. L’anemia che deriva da questo tipo di intossicazione si chiama anemia ipocromica, chi ne soffre produce globuli rossi alterati, definiti “punteggiati”.
Se vi è piaciuto questo articolo continuate a seguirmi anche su Twitter, Facebook, Google+, Instagram
Articoli correlati che possono interessarvi:
- Come disintossicare il corpo dai metalli pesanti
- Intossicazione da mercurio
- Tallio, simbolo e dove si trova
